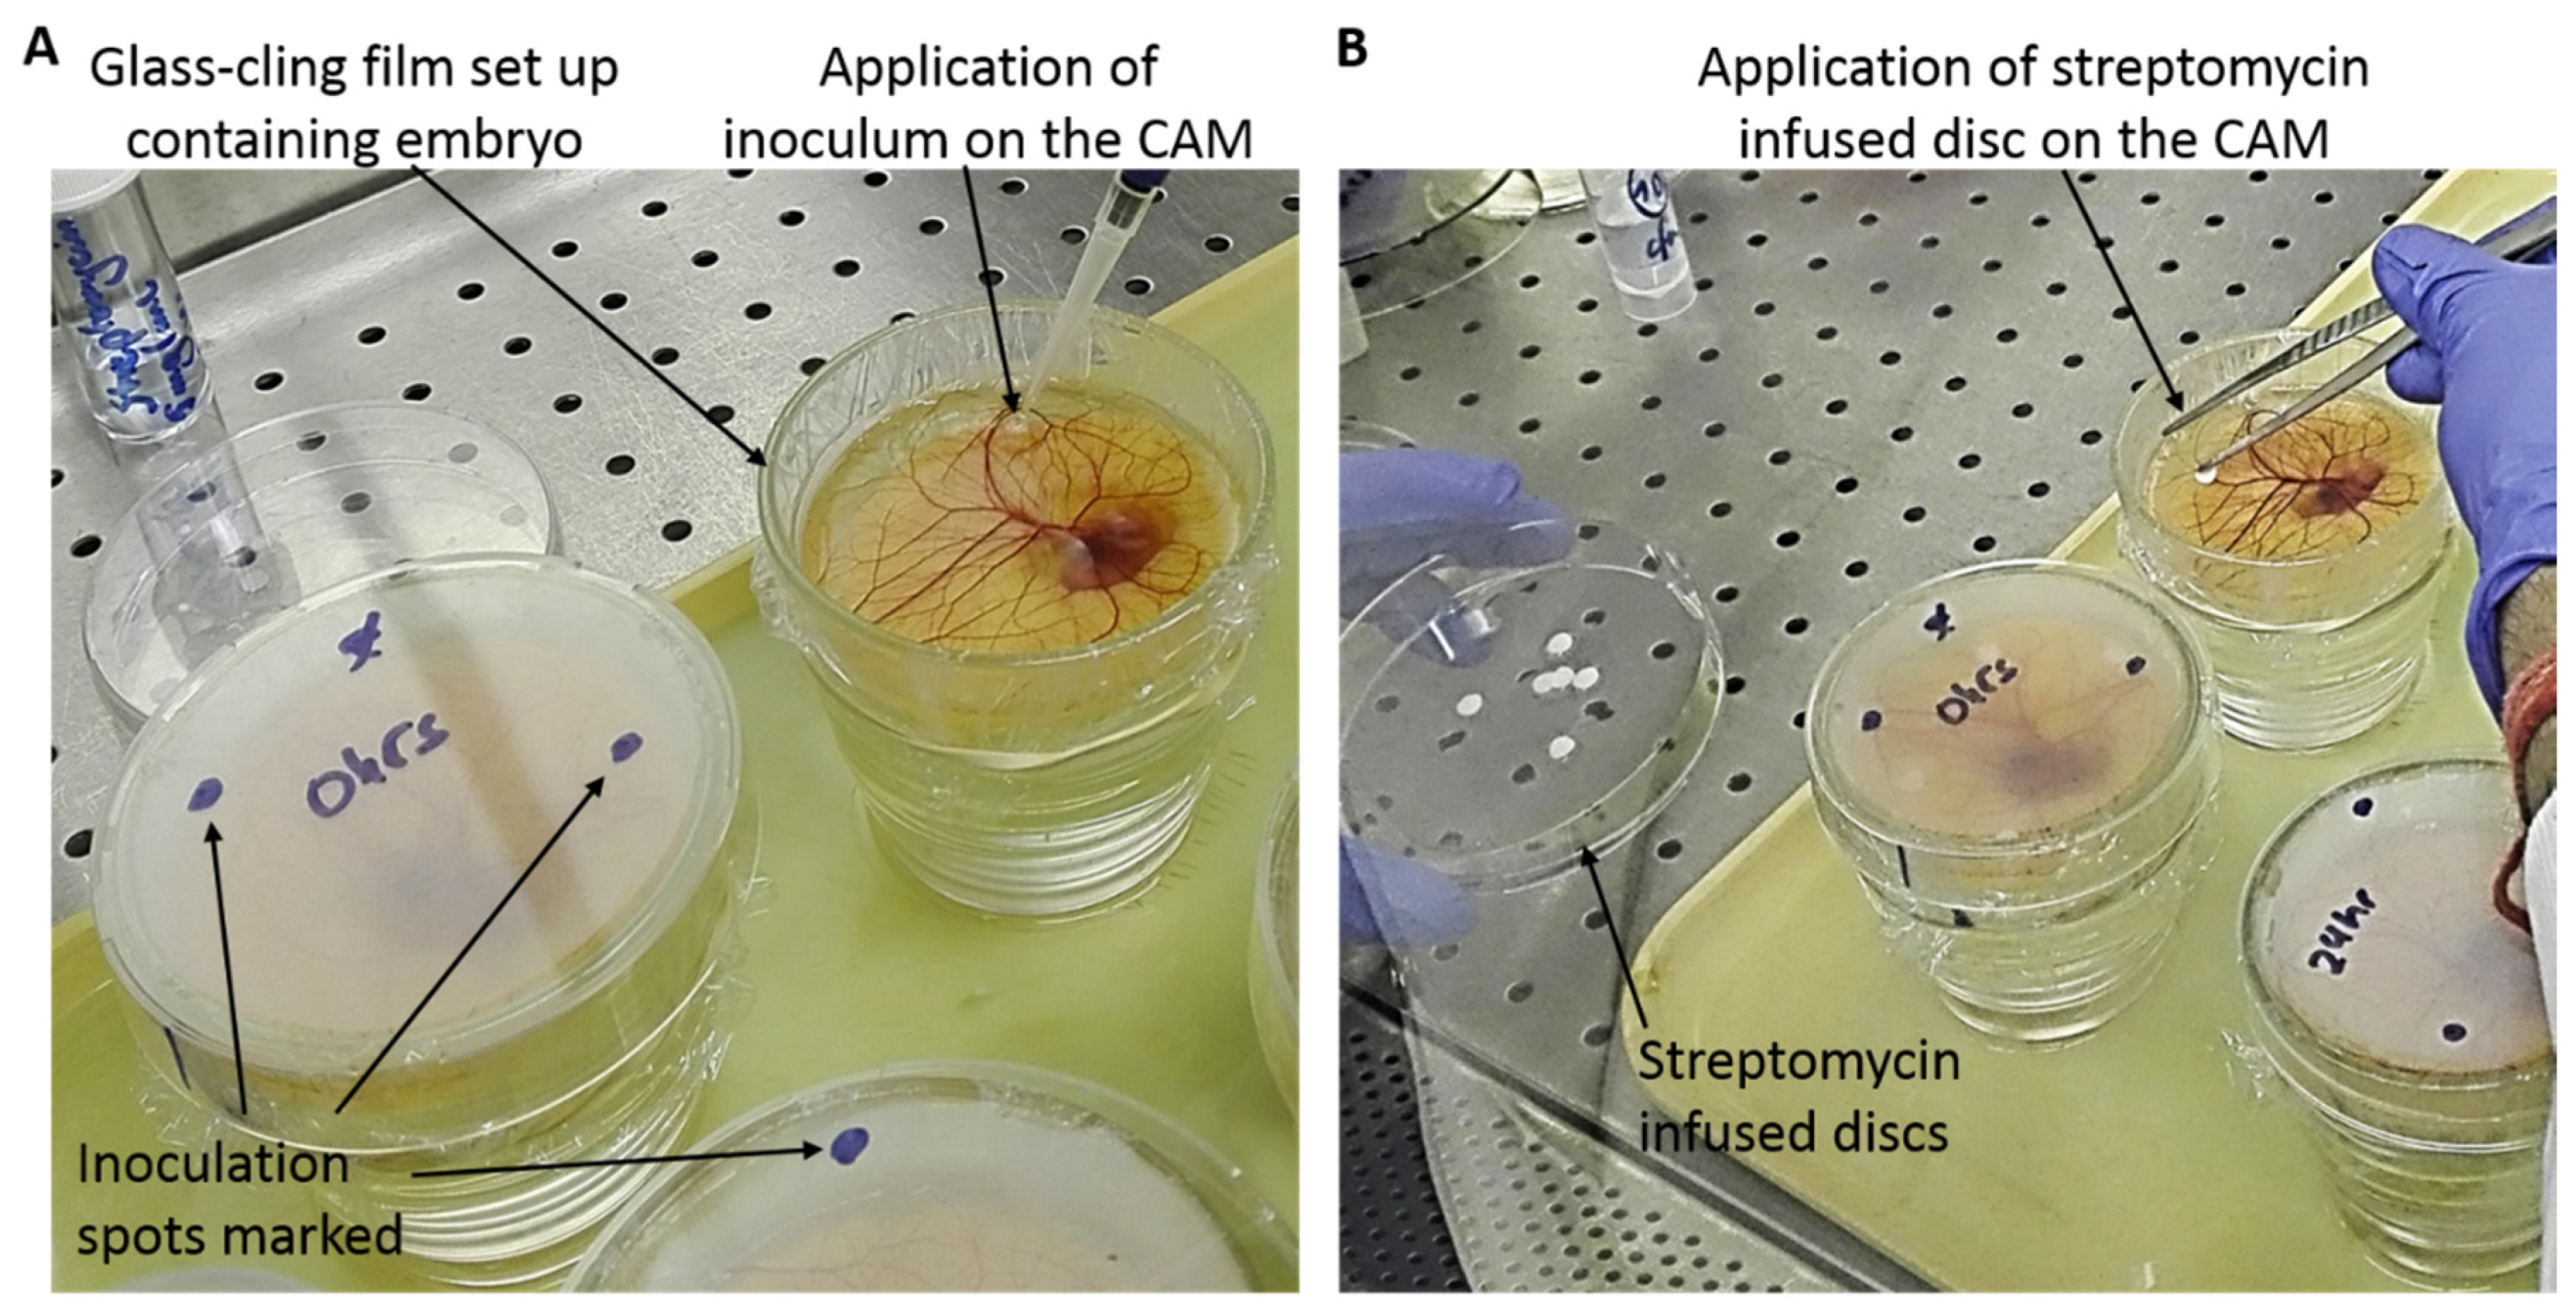
Jfb 11 00037 g001 Jfb 11 00037 g001

Towards the Development of a Novel Ex Ovo Model of Infection to Pre-Screen Biomaterials Intended for Treating Chronic Wounds
Abstract
1. Introduction
2. Materials and Methods
2.1. S. aureus Strains
2.2. Luria-Bertani (LB) Agar Plates
2.3. S. aureus Culture/Colony Isolation
2.4. Streptomycin Sensitivity Assay
2.5. Ex Ovo Culture System
2.6. Ex Ovo CAM Infection with S. aureus
2.7. Preparation and Application of Streptomycin-Infused Discs on CAM
3. Results and Discussion
3.1. Streptomycin Sensitivity Assay
3.2. Embryo Survival after Infection of CAM in the Absence of Streptomycin
3.3. Embryo Survival after Infection of CAM in the Presence of Streptomycin
3.4. CAM Morphology of Infected Embryos
4. Conclusions
Author Contributions
Funding
Conflicts of Interest
References
- Price, A.; Naik, G.; Harding, K. “Skin repair technology”. In Biomaterials for Skin Repair and Regeneration; Woodhead Publishing: Cambridge, UK, 2019; pp. 27–57. [Google Scholar]
- García-Gareta, E. Introduction to biomaterials for skin repair and regeneration. In Biomaterials for Skin Repair and Regeneration; Woodhead Publishing: Cambridge, UK, 2019; pp. xiii–xxvii. [Google Scholar]
- Davison-Kotler, E.; Sharma, V.; Kang, N.V.; García-Gareta, E. A Universal Classification System of Skin Substitutes Inspired by Factorial Design. Tissue Eng. Part B Rev. 2018, 24, 279–288. [Google Scholar] [CrossRef]
- Shevchenko, R.V.; James, S.L.; James, S.E. A review of tissue-engineered skin bioconstructs available for skin reconstruction. J. R. Soc. Interface 2010, 7, 229–258. [Google Scholar] [CrossRef]
- Yuan, Y.J.; Xu, K.; Wu, W.; Luo, Q.; Yu, J.L. Application of the chick embryo chorioallantoic membrane in neurosurgery disease. Int. J. Med. Sci. 2014, 11, 1275–1281. [Google Scholar] [CrossRef]
- Kohli, N.; Sawadkar, P.; Ho, S.; Sharma, V.; Snow, M.; Powell, S.; Woodruff, M.A.; Hook, L.; García-Gareta, E. Pre-screening the intrinsic angiogenic capacity of biomaterials in an optimised ex ovo chorioallantoic membrane model. J. Tissue Eng. 2020, 11. [Google Scholar] [CrossRef]
- Adam, R.; Mussa, S.; Lindemann, D.; Oelschlaeger, T.A.; Deadman, M.; Ferguson, D.J.; Moxon, R.; Schroten, H. The avian chorioallantoic membrane in ovo—A useful model for bacterial invasion assays. Int. J. Med. Microbiol. 2002, 292, 267–275. [Google Scholar] [CrossRef]
- Nnadi, E.N.; Enweani, I.B.; Ayanbimpe, G.M. Infection of Chick Chorioallantoic Membrane (CAM) as a Model for the Pathogenesis of Cryptococcus gattii. Med. Mycol. J. 2018, 59, E25–E30. [Google Scholar] [CrossRef][Green Version]
- Woodruff, A.M.; Goodpasture, E.W. The susceptibiliry of the chorio-allantoic membrane of chick embryos to infection with the fowl-pox virus. Am. J. Pathol. 1931, 7, 209–222. [Google Scholar]
- Gow, N.A.R.; Knox, Y.; Munro, C.A.; Thompson, W.D. Infection of chick chorioallantoic membrane (CAM) as a model for invasive hyphal growth and pathogenesis of Candida albicans. Med. Mycol. 2003, 41, 331–338. [Google Scholar] [CrossRef] [PubMed]
- Serra, R.; Grande, R.; Butrico, L.; Rossi, A.; Settimio, U.F.; Caroleo, B.; Amato, B.; Gallelli, L.; de Franciscis, S. Chronic wound infections: the role of Pseudomonas aeruginosa and Staphylococcus aureus. Expert Rev. Anti. Infect. Ther. 2015, 13, 605–613. [Google Scholar] [CrossRef] [PubMed]
- European Committee on Antimicrobial Susceptibility Testing. European Committee on Antimicrobial Susceptibility Testing Breakpoint Tables for Interpretation of MICs and Zone Diameters; European Committee on Antimicrobial Susceptibility Testing: Växjö, Sweden, 2018.

© 2020 by the authors. Licensee MDPI, Basel, Switzerland. This article is an open access article distributed under the terms and conditions of the Creative Commons Attribution (CC BY) license (http://creativecommons.org/licenses/by/4.0/).
Share and Cite
García-Gareta, E.; Binkowska, J.; Kohli, N.; Sharma, V. Towards the Development of a Novel Ex Ovo Model of Infection to Pre-Screen Biomaterials Intended for Treating Chronic Wounds. J. Funct. Biomater. 2020, 11, 37. https://doi.org/10.3390/jfb11020037
García-Gareta E, Binkowska J, Kohli N, Sharma V. Towards the Development of a Novel Ex Ovo Model of Infection to Pre-Screen Biomaterials Intended for Treating Chronic Wounds. Journal of Functional Biomaterials. 2020; 11(2):37. https://doi.org/10.3390/jfb11020037
Chicago/Turabian StyleGarcía-Gareta, Elena, Justyna Binkowska, Nupur Kohli, and Vaibhav Sharma. 2020. "Towards the Development of a Novel Ex Ovo Model of Infection to Pre-Screen Biomaterials Intended for Treating Chronic Wounds" Journal of Functional Biomaterials 11, no. 2: 37. https://doi.org/10.3390/jfb11020037
APA StyleGarcía-Gareta, E., Binkowska, J., Kohli, N., & Sharma, V. (2020). Towards the Development of a Novel Ex Ovo Model of Infection to Pre-Screen Biomaterials Intended for Treating Chronic Wounds. Journal of Functional Biomaterials, 11(2), 37. https://doi.org/10.3390/jfb11020037

